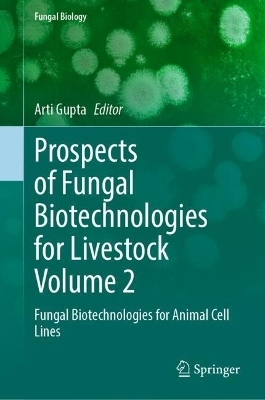
Prospects of Fungal Biotechnologies for Livestock Volume 2 -

Prospects of Fungal Biotechnologies for Livestock Volume 2
Springer International Publishing (Verlag)
978-3-032-06477-6 (ISBN)
This multi-volume set encompasses a substantial amount of research on fungal infections, emphasising relevant data in the discussion. It is intended to address the major causes of fungal biotechnological aspects while bringing in the most recent data concerning discoveries in livestock management. Each volume in the set will provide readers with the necessary information, complemented by the areas of focus outlined in the accompanying volumes. The set covers topics spanning from basic concepts to the health management to engineering using cell lines and approaching the bioprocess technology, with particular focus on recent developments.
Volume 2 is a comprehensive resource on fungal infections, particularly in livestock management. It consolidates extensive research and data on these infections' causes and biotechnological aspects. The content spans from foundational knowledge to advanced topics such as health management and the application of cell line engineering. A significant focus is on bioprocess technology, reflecting the latest advancements in this area. This includes novel diagnostic techniques and emerging therapies that are reshaping the management of fungal diseases in animals. The book also explores current treatments ranging from established antifungal drugs to cutting-edge approaches like nanotechnology-based tools and immunotherapies. By providing a one-source repository of information, the book is a valuable tool for professionals in veterinary medicine, livestock management, and biotechnology research. It addresses the scientific community and offers practical insights for field applications, aiming to bridge the gap between research and real-world challenges in managing fungal infections in livestock.
Dr. Arti Gupta is an Assistant Professor in Department of Biology, Sri Avadh Raj Singh Smarak Degree College, Bishunpur Bairiya, Gonda, India. Dr. Arti received her B.Sc. (CBZ) and M.Sc. in Biotechnology from Chaudhary Charan Singh University, Meerut, India. Dr. Gupta obtained her Ph.D. from Mahatma Jyotiba Phule Rohilkhand University, Bareilly, India. Dr. Gupta’s current research interests are Animal Biotechnology, Molecular Plant Biotechnology, Molecular Animal Biotechnology, Bioprocess Technology, and Microbiology. Dr. Gupta has published 19 edited books, 2 monographs, 52 National and International research papers. Dr. Gupta has been awarded with Gold Medal, M.Sc. (Biotech.), Young Scientist Award, 2 Poster Presenter awards, Fellowship Award awarded by International Consortium of Contemporary Biologist and Dr. V.P. Agarwal Gold Medal awarded. Dr. Arti has a lifetime membership of Indian Science Congress Association, Biotech Research Society of India, Zoological Society of India and International Consortium of Contemporary Biologist.
Structural and Functional Evolution of Streamlined Microsporidia.- Biology and Evolution of Highly Reduced Microsporidia.- Engineering Interventions in Fungal Cell Factories.- Fungal Biotechnology: Contribution to the circular economy. Recycling of waste Sustainability.- Fungal Biotechnology and the Circular Economy.- Fermented food fungal proteins and peptides: past, present and future.- Recent innovations in Myco-Biotechnology: Valourisation of fungal resources for a sustainable and a circular economy.- Filamentous Fungi: Heterologous Protein Expression.- Engineered Fungal Cell Factories: Pioneering Sustainable Protein & Peptide Production.- Fungi as Bioconverters: Advancing Circular Economy through Waste Recycling and Resource Optimization.- The fungal edible proteins industrial biotechnology: where are we?.- An overview about pharmaceutical grade fungal protein and peptides.
| Erscheinungsdatum | 25.11.2025 |
|---|---|
| Reihe/Serie | Fungal Biology |
| Zusatzinfo | XIV, 368 p. 28 illus., 25 illus. in color. |
| Verlagsort | Cham |
| Sprache | englisch |
| Maße | 155 x 235 mm |
| Themenwelt | Naturwissenschaften ► Biologie ► Mikrobiologie / Immunologie |
| Naturwissenschaften ► Biologie ► Mykologie | |
| Schlagworte | animal cell lines • Biotechnology • cell lines • Fungal Biotechnology • Fungal cells • fungal genomics • Fungi |
| ISBN-10 | 3-032-06477-5 / 3032064775 |
| ISBN-13 | 978-3-032-06477-6 / 9783032064776 |
| Zustand | Neuware |
| Informationen gemäß Produktsicherheitsverordnung (GPSR) | |
| Haben Sie eine Frage zum Produkt? |
aus dem Bereich


